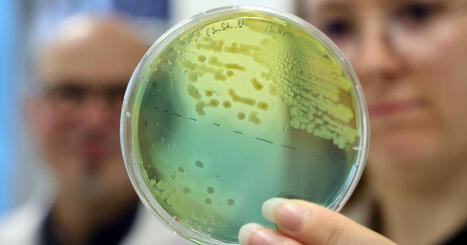
Strasbourg | Des chercheurs r&eacute;unis pour faire face aux enjeux environnementaux du Rhin sup&eacute;rieur | Actu Archi-Urba-Environnement-Paysage | Scoop.it

Your new post is loading...
 Your new post is loading...

|
Scooped by
CAUE d'Alsace
March 20, 11:33 AM
|
Venez partager votre expérience et votre vécu de la Vallée de la Bruche en vous initiant à la cartographie citoyenne. Nul besoin d’être expert·e ! Cet atelier guidé est l’occasion de découvrir la manière dont la carte peut devenir un outil d’expression citoyenne.
La Fresque du Sol est un outil ludique et collaboratif qui vise à diffuser un langage commun sur le fonctionnement des sols, et sur les enjeux liés à leur préservation.
Au travers de 50 cartes et en 3h, il permet de comprendre ce qu’est un sol, comment celui-ci se forme et quelles fonctions écologiques découlent de ses propriétés pour ensuite découvrir l’ensemble des services que l’on en retire, les menaces qui rendent ces services limités dans le temps et l’espace et les actions que l’on peut engager pour préserver le fonctionnement des sols...
Au moyen d’un jeu de rôle, reflétant la diversité des acteurs qui interagissent sur les sols, il ouvre sur une réflexion transversale sur les leviers pour mieux connaitre et préserver les sols.
Via VeilleGestionConnaissances

|
Scooped by
CAUE d'Alsace
March 23, 9:43 AM
|
Au salon Énergie Habitat de Colmar, « le rendez-vous des experts » permet d’éclairer les visiteurs en matière d’aides, dont MaPrimeRénov. Récemment remis à disposition du public, le dispositif est aussi au cœur de l’actualité en raison du procès pour escroquerie qui se tient à Paris. Mais pas de quoi inquiéter les visiteurs.

|
Scooped by
CAUE d'Alsace
March 23, 9:41 AM
|
Les équipes d’Eiffage Énergie Systèmes, branche énergie du groupe Eiffage, troisième groupe de BTP et concessions français, ont investi début mars le nouveau siège régional Est situé dans la zone d’activité Joffre II, au lieu-dit Neubrand, à Holtzheim. Le site se veut énergétiquement vertueux et ambitionne de passer en autoconsommation collective. Une première dans le secteur privé.

|
Scooped by
CAUE d'Alsace
March 20, 11:19 AM
|
"Aujourd’hui de nombreuses communes réaménagent les cours de leurs écoles pour les adapter à la hausse des températures estivales. Cela nécessite d’augmenter les surfaces perméables et d'introduire des solutions fondées sur la nature, avec par exemple des espaces végétalisés et ombragés pour améliorer le confort des usagers. Ces cours d’école renaturées offrent non seulement des espaces de qualité pour leurs usagers, mais également des habitats favorables à l’accueil de la biodiversité, contribuant ainsi à préserver et à favoriser la diversité du vivant dans des milieux artificialisés. Ainsi il est possible d’apporter davantage de bien-être aux usagers tout en favorisant la biodiversité. C’est également une opportunité pour contribuer à l’éducation à l’environnement en proposant un espace de (re)connexion des enfants à la nature. Cette fiche explique comment le réaménagement de cours d’école peut être envisagé pour favoriser la biodiversité et quels sont les outils pour y parvenir. Pour chacun des thèmes exposés, elle est illustrée de retours d’expériences de communes avec l’objectif de donner des clés de réussite pour encourager la réalisation d’autres projets."

|
Scooped by
CAUE d'Alsace
March 20, 11:12 AM
|
La rédaction du « Moniteur » vous propose une sélection quotidienne des textes officiels intéressant le secteur. Au menu : droit de la construction, urbanisme, commande publique et privée, réglementation technique, logement, social…

|
Scooped by
CAUE d'Alsace
March 20, 11:10 AM
|
D’une longueur de 158 m, en quatre travées, la passerelle Rosa-Luxemburg prend forme dans le secteur Citadelle à Strasbourg (Bas-Rhin). Depuis février, les compagnons assemblent les éléments de sa charpente métallique, qui formera d’ici juin un tablier s’élevant jusqu’à 9 m au-dessus du bassin Dusuzeau. La structure en acier sera revêtue de béton fibré à ultra-hautes performances (BFUP). Elle reposera sur des fondations diverses selon la nature du terrain au niveau des différentes culées concernées : pieux battus tubés, pieux forés à tarière creuse ou micro-pieux. Le bow-string, quant à lui, surplombera de 7 m le tablier.

|
Scooped by
CAUE d'Alsace
March 20, 11:07 AM
|
"En 2021, l’équipe municipale de Scharrachbergheim-Irmstett (Bas-Rhin) lançait un concours pour la construction d’une nouvelle mairie. Alors situés au cœur du bourg, ses locaux étaient devenus par trop exigus, avec une accessibilité compliquée pour les PMR. Le site retenu se trouve, lui, en contrebas du village, à la lisière d’un quartier pavillonnaire et de terres agricoles. Afin de limiter aussi bien les volumes à chauffer que la quantité de matériaux nécessaire - et, peut-être plus encore, pour atténuer l’impact visuel sur les riverains -, l’agence d’architecture Al Pepe a imaginé un édifice bas de 300 m², tout en rez-de-chaussée. Un lanterneau central signale néanmoins la présence de l’équipement dans la commune. « Donner au bâtiment un caractère public a guidé notre réponse architecturale, d’où la création de cette émergence en toiture qui le rapproche symboliquement des deux clochers du village », explique Aude Lecinski, cogérante de l’agence strasbourgeoise avec Pascal Philbert."

|
Scooped by
CAUE d'Alsace
March 20, 11:02 AM
|
Dix après Alejandro Aravena, il s’agit du deuxième Chilien récompensé par l’équivalent du Nobel, dans le domaine de l’architecture.

|
Scooped by
CAUE d'Alsace
March 20, 10:55 AM
|
La société Stradim, porteuse d’un projet de lotissement privé comprenant quatre immeubles à Eckwersheim, a tenu mercredi 11 mars une réunion publique d’information. Les questions ont fusé.

|
Scooped by
CAUE d'Alsace
March 20, 10:54 AM
|
"Les travaux de reconversion d’une partie de la friche Orange, à Colmar, se poursuivent. Lentement mais sûrement."

|
Scooped by
CAUE d'Alsace
March 20, 10:53 AM
|
La cité du Houblon, qui a besoin de construire des logements et souhaite garantir son développement économique, doit dans le même temps limiter sa consommation de foncier. Mais la forme que prend l’urbanisation de la ville n’est pas du goût de tout le monde. Revue en quelques points des dynamiques à l’œuvre.

|
Scooped by
CAUE d'Alsace
March 20, 10:52 AM
|
Les membres du Pôle d’équilibre territorial (PETR) de la Bande rhénane nord, regroupant les communautés de communes du Pays rhénan et de la Plaine du Rhin, se sont réunis pour la dernière séance de la mandature au Céram à Soufflenheim ce mercredi 25 février. À l’ordre du jour : le vote du budget et un point sur le Scot approuvé en décembre.
|

|
Scooped by
CAUE d'Alsace
April 10, 9:59 AM
|
Dans le cadre du développement de la phase 2 de ce quartier, la Ville a lancé un appel à manifestation où maîtres d'ouvrage et futurs utilisateurs ont été désignés dans le même temps. Jugé enrichissant mais chronophage, ce processus arrive à son terme.

|
Scooped by
CAUE d'Alsace
March 23, 10:06 AM
|
"Face aux nouvelles règles d’urbanisme, de nombreux propriétaires se sentent démunis : terrains devenus inconstructibles, projets bloqués, décisions publiques difficiles à comprendre. On vous explique. - Zéro artificialisation nette, évolution des PLU, droit de préemption, contestation des permis de construire, construction en zones inondables ou en bord de mer : les règles changent et les marges de manœuvre semblent se réduire.
- Qui décide réellement entre la commune et l’État ?
- Peut-on encore faire construire facilement, contester un projet voisin ou défendre la valeur de son bien ?
- Entre pression foncière, exigences environnementales et multiplication des contentieux, le droit de l’urbanisme se durcit et redessine profondément les droits des particuliers.
- Avec Philippe Jourdan avocat en Droit de l'Urbanisme."

|
Scooped by
CAUE d'Alsace
March 23, 9:42 AM
|
Les écoliers de Sarre-Union et de Harskirchen ont mis tout leur cœur pour planter une haie en pleine pâture mardi 17 mars. Une façon concrète de les sensibiliser à l’avenir de la planète à travers un important projet mené par le Parc naturel régional des Vosges du Nord, la Grange aux paysages et Anthony Lang, agriculteur.

|
Scooped by
CAUE d'Alsace
March 20, 11:30 AM
|
- Simplification : ce que prévoit le méga-décret - Taxe d’Aménagement : pour le Conseil d’État, les parkings en terre battue sont inclus - Obligations légales de débroussaillement : une dérogation Espèces protégées peut être requise - Les dysfonctionnements d'une station d'épuration peuvent entraîner l'annulation d'un Plan Local d'Urbanisme - Pour se prononcer sur les demandes de dérogations aux règles relatives aux destinations dans les PLU, le délai peut-il être allongé ? - Abattage d’alignement d’arbres : le permis délivré par le maire ne vaut pas dérogation - Permis d’Aménager : jusqu’où peut-on aller dans la décision ?

|
Scooped by
CAUE d'Alsace
March 20, 11:18 AM
|
Un ouvrage collectif sur la nature en ville est publié ce 19 mars 2026 : en croisant les regards sur la construction des démarches de nature en ville, l’objectif est de mettre en perspective, d’interroger et de comprendre le mécanisme de production de la nature en ville, la gouvernance de ces projets, l’intégration des dimensions environnementales et sociales.
Il propose des analyses, des retours d’expérience, donne à réfléchir sur les enjeux, la conception et la mise en œuvre de la nature en ville, et présente des pistes pour faire évoluer les pratiques.

|
Scooped by
CAUE d'Alsace
March 20, 11:11 AM
|
Cette ouverture constitue une phase de la reconversion d’un site d’environ deux hectares, pilotée et engagée par la collectivité dans le cadre d’un projet urbain global. L’accueil du public débutera le 2 mars 2026.
Baptisé « Pixel », l’équipement occupe l’ancienne cantine des officiers, réhabilitée pour accueillir des activités nouvelles et des dispositifs locaux. Il offre 300 m² dédiés à l’apprentissage, à la médiation numérique et aux initiatives culturelles locales. Une Maison du projet y présentera, de façon permanente, les opérations de renouvellement urbain prévues dans le secteur, notamment au moyen de maquettes en trois dimensions. Des ateliers, rencontres et événements seront proposés dès l’ouverture.

|
Scooped by
CAUE d'Alsace
March 20, 11:08 AM
|
Avec son bardage en bois et ses tons sable et brun, le nouveau gymnase Brant s’intègre harmonieusement dans le quartier Saint-Vincent-de-Paul, dans le nord-ouest de Colmar (Haut-Rhin). Inaugurée en janvier, l’opération d’un coût de 8,40 M€ signe la dernière étape marquante du renouvellement urbain de ce quartier prioritaire de la politique de la ville. Ce dernier aura bénéficié, de 2017 à 2030, de travaux d’un montant de 37,3 M€ HT prévoyant la démolition de 509 logements ainsi que 191 reconstructions.

|
Scooped by
CAUE d'Alsace
March 20, 11:03 AM
|
Le dispositif « Jeanbrun », pensé comme un mécanisme d’avantage fiscal destiné à doper la construction, ne prend pas en compte la qualité des logements produits, estiment de nombreux architectes.

|
Scooped by
CAUE d'Alsace
March 20, 10:56 AM
|
Un peu comme un Giec (groupe d’experts intergouvernemental sur l’évolution du climat) décliné à l’échelle régionale, la création à l’université de Strasbourg de l’institut thématique interdisciplinaire “Switch” entend répondre aux enjeux socioenvironnementaux actuels et à venir dans le Rhin supérieur avec l’aide d’entreprises et de collectivités. Des enjeux qui ont un impact direct sur notre santé.

|
Scooped by
CAUE d'Alsace
March 20, 10:55 AM
|
Le ministère de la Culture a octroyé le label “Architecture contemporaine remarquable” au complexe culturel et festif des Tanzmatten de Sélestat. La plaque a été dévoilée jeudi 5 mars par Marcel Bauer, maire de Sélestat, en présence de Jean-Jacques Renaudet, ancien adjoint à la culture lors du lancement du projet, et d’Eric Cakpo, l’actuel adjoint à la culture.

|
Scooped by
CAUE d'Alsace
March 20, 10:54 AM
|
Après un an de travaux, la réfection du toit du tribunal judiciaire de Strasbourg vient d’être achevée. L’impressionnant échafaudage, qui entourait le bâtiment, a été retiré. Les pluies de ces dernières semaines ont éprouvé la réalisation : le problème d’infiltrations semble réglé pour de bon.

|
Scooped by
CAUE d'Alsace
March 20, 10:53 AM
|
Lors du débat d’orientation budgétaire, mercredi 4 mars, les élus de la communauté de communes de l’Outre-Forêt ont présenté les perspectives de 2026. Les investissements prévus iront surtout vers les pistes cyclables, la construction de la future crèche de Betschdorf, les périscolaires et le futur parc d’excellence industriel.
|






 Your new post is loading...
Your new post is loading...